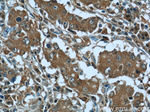
RRP7A Antibody in Immunohistochemistry (Paraffin) (IHC (P))

Search
Proteintech
RRP7A Polyclonal Antibody
{{$productOrderCtrl.translations['antibody.pdp.commerceCard.promotion.promotions']}}
{{$productOrderCtrl.translations['antibody.pdp.commerceCard.promotion.viewpromo']}}
{{$productOrderCtrl.translations['antibody.pdp.commerceCard.promotion.promocode']}}: {{promo.promoCode}} {{promo.promoTitle}} {{promo.promoDescription}}. {{$productOrderCtrl.translations['antibody.pdp.commerceCard.promotion.learnmore']}}
产品信息
24490-1-AP
种属反应
宿主/亚型
分类
类型
抗原
偶联物
形式
浓度
规格
纯化类型
保存液
内含物
保存条件
运输条件
产品详细信息
Immunogen sequence: MVARRRKCA ARDPEDRIPS PLGYAAIPIK FSEKQQASHY LYVRAHGVRQ GTKSTWPQKR TLFVLNVPPY CTEESLSRLL STCGLVQSVE LQEKPDLAES PKESRSKFFH PKPVPGFQVA YVVFQKPSGV SAALALKGPL LVSTESHPVK SGIHKWISDY ADSVPDPEAL RVEVDTF (1-176 aa encoded by BC121118)
靶标信息
RRP7A (Ribosomal RNA Processing 7 Homolog A) is a Protein Coding gene. Diseases associated with RRP7A include Autosomal Dominant Non-Syndromic Intellectual Disability 1 and Autosomal Dominant Non-Syndromic Intellectual Disability. Among its related pathways are rRNA processing in the nucleus and cytosol and Gene Expression. Gene Ontology (GO) annotations related to this gene include nucleotide binding. [GeneCards]
仅用于科研。不用于诊断过程。未经明确授权不得转售。
篇参考文献 (0)
生物信息学
蛋白别名: CGI-96 protein; CTA-126B4.5; Gastric cancer antigen Zg14; Gastric cancer antigen Zg14 homolog; kidney highly expressed protein 1; Ribosomal RNA-processing protein 7 homolog A; unnamed protein product
基因别名: 1110014J01Rik; AA408146; BK126B4.3; CGI-96; Kheg1; MCPH28; Rrp7; RRP7A
UniProt ID: (Human) Q9Y3A4, (Mouse) Q9D1C9
Entrez Gene ID: (Human) 27341, (Mouse) 74778